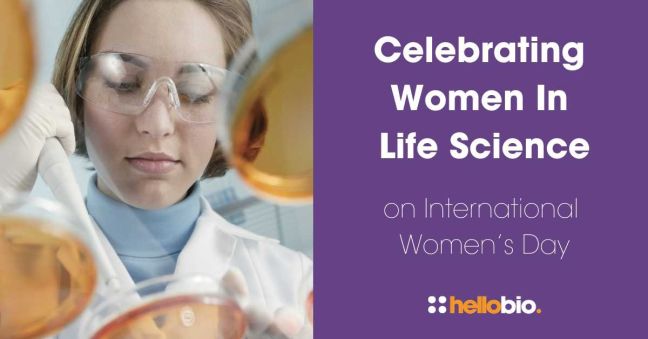
Celebrating Women In Life Science on International Women’s Day

10 Award-Winning Female Scientists of 2024
As we head towards the end of another busy year, it’s clear to see that 2024 has been a year of outstanding scientific research and discovery. Scientists around the world have been recognised for their outstanding contributions to STEM, and praised for their resilience and determination in the face of an ongoing spread of disinformation, mistrust, and political unrest.
All scientists deserve to be celebrated and recognised for their hard work, and we should be cheering especially loud for those from underrepresented or minority groups. That’s why we were disappointed to see that not a single female researcher was awarded a Nobel Prize in the Sciences in 2024!
So we’ve decided to shine a spotlight on a few of the many inspiring women in STEM who did win awards in 2024, including a molecular biologist, a stem cell expert, a breast cancer specialist and a tropical disease researcher!
Take a look at our list of 10 Award-Winning Female Scientists of 2024, and don’t forget to nominate your favourite life science colleague in the Hello Bio Lab Heroes Awards 2024!
1. Professor Meritxell Huch
Award: Otto Bayer Award 2024
The renowned German research award, the Otto Bayer, was this year presented to Professor Meritxell Huch of the Max Planck Institute of Molecular Cell Biology and Genetics. The award celebrates scientists working in German-speaking countries who demonstrate ground-breaking work in chemistry or biochemistry. Professor Huch is a stem cell biologist who is known for her work on human organoids, with pioneering research that is aiding the development of new treatments for life-threatening cancers. She is a director at the Max Planck Institute and she adds this award to an impressive collection which includes the Hamdan Award for Medical Excellence, the Women in Cell Science Prize of the British Society, the EMBO Young Investigator Award and the BINDER Prize.
2. Anne Ephrussi
Award: FEBS | EMBO Women in Science Award 2024
Anne Ephrussi, is a French developmental and molecular biologist, and is this year’s recipient of the FEBS | EMBO Women in Science Award. The annual prize recognises the research achievements of outstanding female life scientists in Europe, and Ephrussi received the award for elucidating mechanisms of mRNA transport from the site of transcription to specific locations within polarised cells and the regulation of translation. She has spent much of her career at the European Molecular Biology Laboratory (EMBL) where she served as head of the Developmental Biology Unit from 2007 to 2021, and is considered an inspiring role model due to her commitment to mentoring and training of life scientists.
3. Dr Margaret A. Pericak-Vance
Award: ASHG Lifetime Achievement Award 2024
The American Society of Human Genetics named Dr Margaret A. Pericak-Vance as one of this year’s recipients of an ASHG Lifetime Achievement Award. The prize celebrates scientists who have made a significant contribution to human genetics, and Dr Pericak-Vance is a leading genetics and genomics researcher whose work focuses on mapping Mendelian and complex genetic disorders. Over the years her research has led to findings of genes that increase the risk of Alzheimer’s and multiple sclerosis, and she is the recipient of numerous other awards including the Hauptman-Woodward Pioneer of Science Award and the American Association for the Advancement of Science Award.
4. Dr Fiona M Watt
Award: ISSCR Achievement Award 2024
Fiona M Watt is British scientist who is internationally recognised for her work in the field of skin and stem cell biology. This year she was the recipient of the ISSCR Achievement Award which celebrates scientists who have had a significant impact on the field of stem cell research or regenerative medicine. As the leader of a research group at EMBL in Heidelberg, Germany, her work has uncovered the plasticity of epidermal stem cells, pioneer single cell analysis, and resulted in new insights into epidermal deregulation and its impact on tumour formation. She adds this award to a huge collection of honours which include the Hunterian Society Medal, the Suffrage Science Award and the FEBS/EMBO Women in Science Award.
5. Professor Yan Ning (Nieng Yan)
Award: 2024 L'Oréal-UNESCO For Women in Science International Award
The International L’Oréal-UNESCO Awards were created in 1998 to celebrate exceptional female scientists and their contributions to the progress of science. This year’s winners included Yan Ning (Nieng Yan), a Chinese scientist at the School of Life Sciences, Tsinghua University. A leading authority in her field, she was recognised for her research which led to the discovery of the atomic structure of multiple membrane proteins that mediate the traffic of ions and sugars across the cell membrane. Her work has seen advancements in epilepsy and arrhythmia treatments, and she is a passionate advocate for gender equality in science research and education.
6. Professor Nancy Kanwisher
Award: 2024 Kavli Prize in Neuroscience
Nancy Kanwisher is an American professor of cognitive neuroscience, and is one of three recipients of this year’s Kavli Prize in Neuroscience. The biennial award recognises scientists for their research into the understanding of the human brain, and along with Winrich Freiwald and Doris Tsao, Professor Kanwisher is recognised for her contribution to the studies which discovered a localised and specialised neocortical system for face recognition. This year also saw her jointly awarded the Rosenstiel Award of Brandeis University for distinguished work in basic medical research.
7. Dr Funmi Olopade
Award: Ellis Medal of Honor 2024
Dr Olufunmilayo Olopade is a Nigerian hematology oncologist and breast cancer researcher based at the University of Chicago Medicine, USA. She is internationally renowned for her research expertise, and was this year’s winner of the Ellis Medal of Honor, a prestigious award that recognises Americans of immigrant descent who have made a significant contribution to society. Her latest landmark study into breast cancer in women of African descent has identified new genetic variants and represents a significant breakthrough for breast cancer genetics research.
8. Professor Maria Grazia Spillantini
Award: Mika Salpeter Lifetime Achievement Award
This year the Society for Neuroscience (SfN) presented the annual Mika Salpeter Lifetime Achievement Award to the Italian molecular neurologist Maria Grazia Spillantini. The award celebrates the achievements of neuroscience researchers who have significantly promoted the advancement of women in neuroscience. Professor Spillantini carries out her research in the Department of Clinical Neurosciences at the University of Cambridge, and is best known for identifying the protein alpha-synuclein as a main component of Lewy bodies, a protein deposit found in the brain in cases of Parkinson’s disease and dementia. She is widely celebrated for advancing new treatment possibilities in a variety of degenerative diseases.
9. Cornelia I Bargmann
Award: 2024 Gruber Neuroscience Prize
The Gruber Foundation’s annual Neuroscience Prize recognises scientists who have made major discoveries which have advanced the understanding of the nervous system. This year’s joint winner was Cornelia I Bargmann of the Rockefeller University in New York, USA, who along with Gerald M Rubin, was honoured for her work in delineating the circuitry of behaviour and developing valuable research tools which have benefited the entire neuroscience research community. She’s a highly regarded neurobiologist who already has an impressive list of accolades to her name, including the Breakthrough Prize in Life Sciences, the Benjamin Franklin Medal in Life Sciences and the Salk Medal for Research Excellence.
10. Dr Claire Chewapreecha
Award: 2024 Nature Awards for Inspiring Women in Science (Scientific Achievement)
This year’s winner of the Nature Awards for Inspiring Women in Science (Scientific Achievement) was Claire Chewapreecha of the MORU Mahidol Oxford Tropical Medicine Research Unit. The award recognises scientists who have made an exceptional contribution to science and who have made efforts to inspire the next generation of women in STEM. Dr Chewapreecha is a bacterial genomics expert and computational biologist who is based in Thailand and uses genomics to fight melioidosis, a tropical disease with a 10-50% fatality rate. Her long-term goal is to build a sustainable genomic research programme for melioidosis and other infectious diseases in Thailand.
More inspiring articles on women in STEM
If you’d like to read more about some of the great female scientists, past and present, as well as issues affecting women in STEM, take a look at some of these other resources on the Hello Bio blog:
- Words of Wisdom from Women in STEM
- 10 Award-Winning Female Scientists You Should Know About
- Ten Inspiring Women in Science History
- Supporting Women in STEM - Resources for Female Researchers
- Ten Effective Support Networks for Women in STEM
- Gender Bias from a Woman in Science - guest blog by Kay M. Tye
- Overcoming Challenges as a Woman in STEM - guest blog by Gagandeep Kaur
- Promoting Diversity in STEM Online - guest blog by Mackenzie Lemieux and Rebecca Zhang
- 10 Tips for Balancing Parenthood on the Path to Your PhD - guest blog by Laura Geben
__________________________
If you enjoyed this article, why not check out the other resources available on our blog. We are passionate about supporting life scientists including early career life scientists and PhD students - with really low-priced reagents, antibodies and biochemicals, early career scientist grants, and resources to help with both personal and professional development. We know how tough it is - so we hope you find these helpful!
More General Support for Life Scientists
For advice on wellbeing, dissertations, presenting at conferences, wellbeing, PhD support, networking and lots more, we have a huge range of articles to help - just click below:
Save up to 50% on our high purity reagents...
When you get to the stage of planning your experiments, don't forget that we offer a range of low-cost, high-purity agonists, antagonists, inhibitors, activators, antibodies and fluorescent tools (yes - they really are around half the price of other suppliers!) You can use our Quick Multi-Search Tool to search for lots of products in one go, and the range includes:
- Enzyme inhibitors and activators
- Chemogenetic ligands
- Ion channel modulators
- GPCR & ionotropic receptor ligands
- Cell biology reagents & biochemicals
Technical resources
Try our Molarity Calculator: a quick and easy way to calculate the mass, volume or concentration required for making a solution.
Try our Dilution Calculator: an easy way to work out how to dilute stock solutions of known concentrations
We also offer a comprehensive range of technical resources including antibody protocols and methods, product guides and mini-reviews:
And finally, don't forget to check back in with our blog regularly for our latest articles. If there’s something you’d love to contribute to the community, whether that’s an interview or article, drop us a line at hello@m2stage.hellobio.com
---